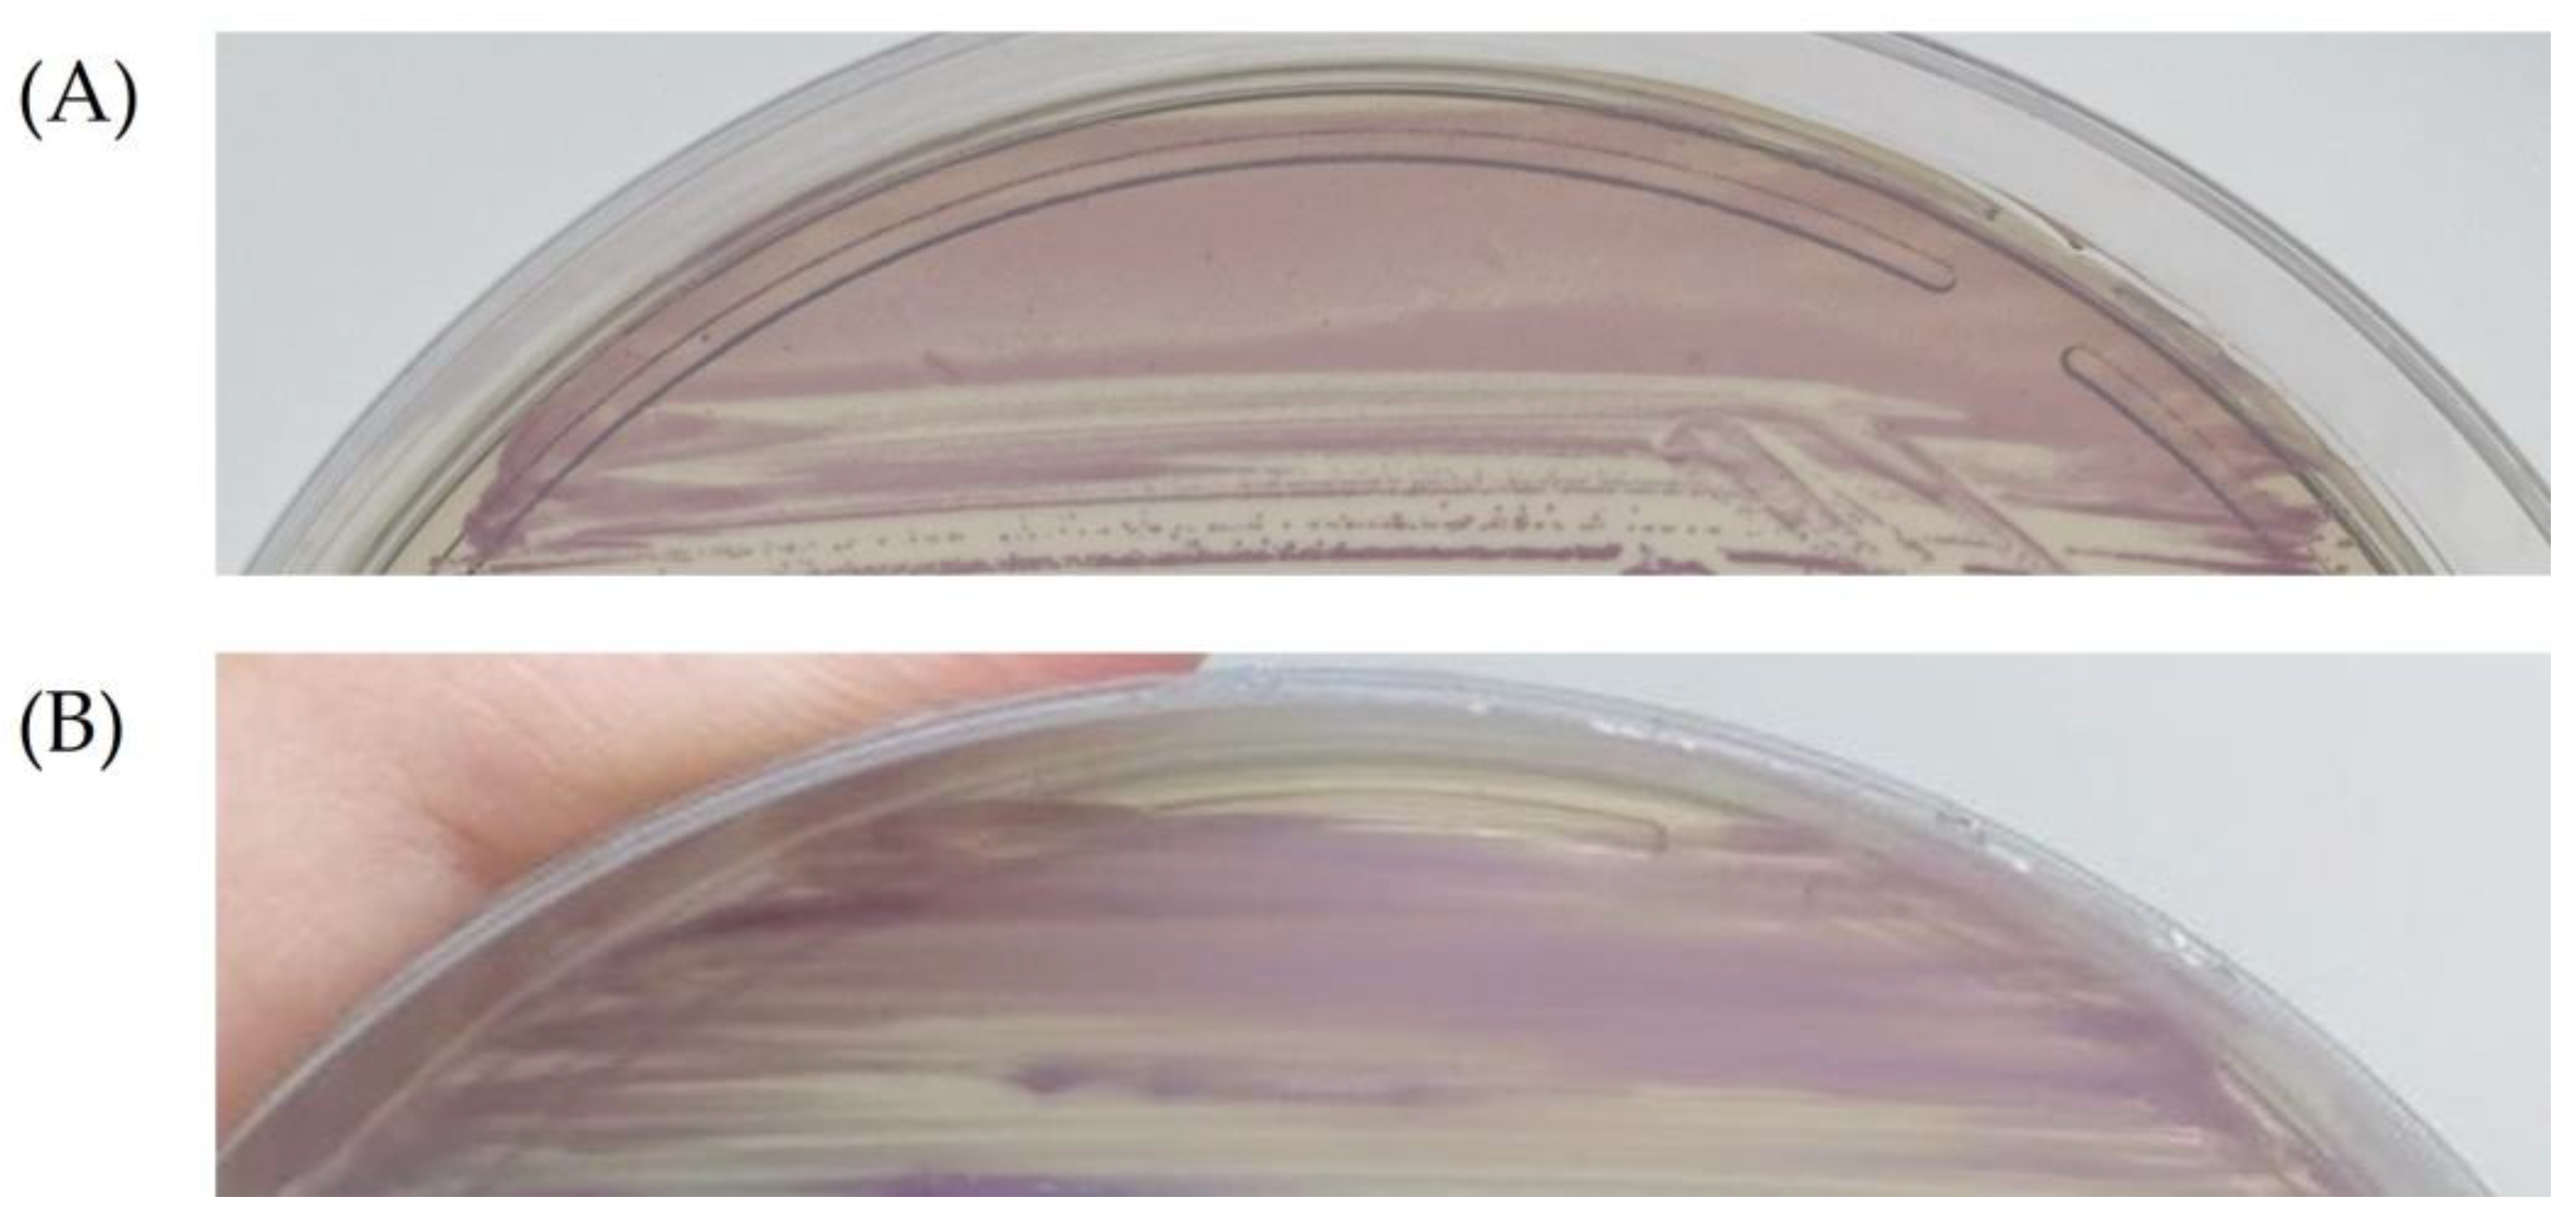
Antibiotics 13 00085 g001

Anovaginal Colonization by Group B Streptococcus and Streptococcus anginosus among Pregnant Women in Brazil and Its Association with Clinical Features
Abstract
1. Introduction
2. Results
3. Discussion
4. Materials and Methods
4.1. Population Included in the Study
4.2. Collection of Clinical Specimens and Detection of GBS and S. anginosus
4.3. Statistical Analysis
5. Conclusions
Author Contributions
Funding
Institutional Review Board Statement
Informed Consent Statement
Data Availability Statement
Acknowledgments
Conflicts of Interest
References
- World Health Organization. Group B Streptococcus Vaccine: Full Value Vaccine Assessment. Available online: https://www.who.int/publications-detail-redirect/9789240037526 (accessed on 22 April 2022).
- Seale, A.C.; Bianchi-Jassir, F.; Russell, N.J.; Kohli-Lynch, M.; Tann, C.J.; Hall, J.; Madrid, L.; Blencowe, H.; Cousens, S.; Baker, C.J.; et al. Estimates of the Burden of Group B Streptococcal Disease Worldwide for Pregnant Women, Stillbirths, and Children. Clin. Infect. Dis. 2017, 65, S200–S219. [Google Scholar] [CrossRef]
- Zanini da Rocha, J.; Feltraco, J.; Radin, V.; Vitola Gonçalves, C.; Almeida da Silva, P.E.; Von Groll, A. Streptococcus Agalactiae Colonization and Screening Approach in High-Risk Pregnant Women in Southern Brazil. J. Infect. Dev. Ctries. 2020, 14, 332–340. [Google Scholar] [CrossRef] [PubMed]
- Costa, N.S.; Oliveira, L.M.A.; Meštrović, T.; Obiero, C.W.; Lee, S.S.; Pinto, T.C.A. The Urgent Need to Recognize and Properly Address Prenatal-Onset Group B Streptococcus Disease. Int. J. Infect. Dis. 2022, 124, 168–170. [Google Scholar] [CrossRef] [PubMed]
- Asam, D.; Spellerberg, B. Molecular Pathogenicity of Streptococcus anginosus. Mol. Oral Microbiol. 2014, 29, 145–155. [Google Scholar] [CrossRef]
- Reißmann, S.; Friedrichs, C.; Rajkumari, R.; Itzek, A.; Fulde, M.; Rodloff, A.C.; Brahmadathan, K.N.; Chhatwal, G.S.; Nitsche-Schmitz, D.P. Contribution of Streptococcus anginosus to Infections Caused by Groups C and G Streptococci, Southern India. Emerg. Infect. Dis. 2010, 16, 656–663. [Google Scholar] [CrossRef] [PubMed]
- Kobo, O.; Nikola, S.; Geffen, Y.; Paul, M. The Pyogenic Potential of the Different Streptococcus anginosus Group Bacterial Species: Retrospective Cohort Study. Epidemiol. Infect. 2017, 145, 3065–3069. [Google Scholar] [CrossRef] [PubMed]
- Laupland, K.B.; Pasquill, K.; Parfitt, E.C.; Dagasso, G.; Steele, L. Streptococcus anginosus Group Bloodstream Infections in the Western Interior of British Columbia, Canada. Infect. Dis. 2018, 50, 423–428. [Google Scholar] [CrossRef]
- Jiang, S.; Li, M.; Fu, T.; Shan, F.; Jiang, L.; Shao, Z. Clinical Characteristics of Infections Caused by Streptococcus anginosus Group. Sci. Rep. 2020, 10, 9032. [Google Scholar] [CrossRef]
- Obszańska, K.; Kern-Zdanowicz, I.; Kozińska, A.; Machura, K.; Stefaniuk, E.; Hryniewicz, W.; Sitkiewicz, I. Streptococcus anginosus (Milleri) Group Strains Isolated in Poland (1996–2012) and Their Antibiotic Resistance Patterns. Pol. J. Microbiol. 2016, 65, 33–41. [Google Scholar] [CrossRef]
- Baracco, G.J. Infections Caused by Group C and G Streptococcus (Streptococcus dysgalactiae Subsp. equisimilis and Others): Epidemiological and Clinical Aspects. Microbiol. Spectr. 2019, 7. [Google Scholar] [CrossRef]
- Clarridge, J.E.; Attorri, S.; Musher, D.M.; Hebert, J.; Dunbar, S. Streptococcus Intermedius, Streptococcus constellatus, and Streptococcus anginosus (“Streptococcus milleri Group”) Are of Different Clinical Importance and Are Not Equally Associated with Abscess. Clin. Infect. Dis. 2001, 32, 1511–1515. [Google Scholar] [CrossRef] [PubMed]
- Rashid, R.M.; Salah, W.; Parada, J.P. “Streptococcus milleri” Aortic Valve Endocarditis and Hepatic Abscess. J. Med. Microbiol. 2007, 56, 280–282. [Google Scholar] [CrossRef] [PubMed]
- Tao, Z.; Zhang, L.; Zhang, Q.; Lv, T.; Chen, R.; Wang, L.; Huang, Z.; Hu, L.; Liao, Q. The Pathogenesis of Streptococcus anginosus In Aerobic Vaginitis. Infect. Drug Resist. 2019, 12, 3745–3754. [Google Scholar] [CrossRef]
- Cox, R.A.; Chen, K.; Coykendall, A.L.; Wesbecher, P.; Herson, V.C. Fatal Infection in Neonates of 26 Weeks’ Gestation Due to Streptococcus milleri: Report of Two Cases. J. Clin. Pathol. 1987, 40, 190–193. [Google Scholar] [CrossRef]
- Kaambo, E.; Africa, C.W.J. The Threat of Aerobic Vaginitis to Pregnancy and Neonatal Morbidity. Afr. J. Reprod. Health 2017, 21, 108–118. [Google Scholar] [CrossRef] [PubMed]
- Simoes, J.A.; Alves, V.M.N.; Fracalanzza, S.E.L.; de Camargo, R.P.S.; Mathias, L.; Milanez, H.M.B.P.; Brolazo, E.M. Phenotypical Characteristics of Group B Streptococcus in Parturients. Braz. J. Infect. Dis. 2007, 11, 261–266. [Google Scholar] [CrossRef][Green Version]
- Linhares, J.J.; Cavalcante Neto, P.G.; Vasconcelos, J.L.M.; Saraiva, T.d.V.; Ribeiro, A.M.F.; Siqueira, T.M.; Rocha, F.R. Prevalência de colonização por Streptococcus agalactiae em gestantes atendidas em maternidade do Ceará, no Brasil, correlacionando com os resultados perinatais. Rev. Bras. Ginecol. Obstet. 2011, 33, 395–400. [Google Scholar]
- Botelho, A.C.N.; Oliveira, J.G.; Damasco, A.P.; Santos, K.T.B.; Ferreira, A.F.M.; Rocha, G.T.; Marinho, P.S.; Bornia, R.B.G.; Pinto, T.C.A.; Américo, M.A.; et al. Streptococcus Agalactiae Carriage among Pregnant Women Living in Rio de Janeiro, Brazil, over a Period of Eight Years. PLoS ONE 2018, 13, e0196925. [Google Scholar] [CrossRef]
- Costa, N.S.; Rio-Tinto, A.; Ferreira Pinto, I.B.; dos Santos Silva Alvim, D.C.; Rocha, A.d.A.; Andrade Oliveira, L.M.; Nunes Botelho, A.C.; Longo Fracalanzza, S.E.; Teixeira, L.M.; Rezende-Filho, J.; et al. Changes in Group B Streptococcus Colonization among Pregnant Women before and after the Onset of the COVID-19 Pandemic in Brazil. Pathogens 2022, 11, 1104. [Google Scholar] [CrossRef]
- Pilarczyk-Zurek, M.; Sitkiewicz, I.; Koziel, J. The Clinical View on Streptococcus anginosus Group—Opportunistic Pathogens Coming Out of Hiding. Front. Microbiol. 2022, 13, 956677. [Google Scholar] [CrossRef]
- Ksiezarek, M.; Ugarcina-Perovic, S.; Rocha, J.; Grosso, F.; Peixe, L. Long-Term Stability of the Urogenital Microbiota of Asymptomatic European Women. BMC Microbiol. 2021, 21, 64. [Google Scholar] [CrossRef] [PubMed]
- Nunn, K.L.; Witkin, S.S.; Schneider, G.M.; Boester, A.; Nasioudis, D.; Minis, E.; Gliniewicz, K.; Forney, L.J. Changes in the Vaginal Microbiome during the Pregnancy to Postpartum Transition. Reprod. Sci. 2021, 28, 1996–2005. [Google Scholar] [CrossRef] [PubMed]
- Juliana, N.C.A.; Deb, S.; Juma, M.H.; Poort, L.; Budding, A.E.; Mbarouk, A.; Ali, S.M.; Ouburg, S.; Morré, S.A.; Sazawal, S.; et al. The Vaginal Microbiota Composition and Genital Infections during and after Pregnancy among Women in Pemba Island, Tanzania. Microorganisms 2022, 10, 509. [Google Scholar] [CrossRef] [PubMed]
- Pearce, M.M.; Hilt, E.E.; Rosenfeld, A.B.; Zilliox, M.J.; Thomas-White, K.; Fok, C.; Kliethermes, S.; Schreckenberger, P.C.; Brubaker, L.; Gai, X.; et al. The Female Urinary Microbiome: A Comparison of Women with and without Urgency Urinary Incontinence. mBio 2014, 5, e01283–e01314. [Google Scholar] [CrossRef]
- Joyce, C.; Halverson, T.; Gonzalez, C.; Brubaker, L.; Wolfe, A.J. The Urobiomes of Adult Women with Various Lower Urinary Tract Symptoms Status Differ: A Re-Analysis. Front. Cell. Infect. Microbiol. 2022, 12, 860408. [Google Scholar] [CrossRef] [PubMed]
- Whiley, R.A.; Beighton, D.; Winstanley, T.G.; Fraser, H.Y.; Hardie, J.M. Streptococcus Intermedius, Streptococcus constellatus, and Streptococcus anginosus (the Streptococcus milleri Group): Association with Different Body Sites and Clinical Infections. J. Clin. Microbiol. 1992, 30, 243–244. [Google Scholar] [CrossRef] [PubMed]
- Furuichi, M.; Horikoshi, Y. Sites of Infection Associated with Streptococcus anginosus Group among Children. J. Infect. Chemother. 2018, 24, 99–102. [Google Scholar] [CrossRef]
- Streptococcus Lab: Id Strep Species General Methods Section 2|CDC. Available online: https://www.cdc.gov/streplab/other-strep/general-methods-section2.html (accessed on 7 October 2023).
- Woods, K.; Beighton, D.; Klein, J.L. Identification of the “Streptococcus anginosus Group” by Matrix-Assisted Laser Desorption Ionization–Time-of-Flight Mass Spectrometry. J. Med. Microbiol. 2014, 63, 1143–1147. [Google Scholar] [CrossRef]
- Campisciano, G.; Zanotta, N.; Petix, V.; Corich, L.; De Seta, F.; Comar, M. Vaginal Microbiota Dysmicrobism and Role of Biofilm-Forming Bacteria. Front. Biosci. 2018, 10, 528–536. [Google Scholar] [CrossRef]
- Brunner, A.; Medvecz, M.; Makra, N.; Sárdy, M.; Komka, K.; Gugolya, M.; Szabó, D.; Gajdács, M.; Ostorházi, E. Human Beta Defensin Levels and Vaginal Microbiome Composition in Post-Menopausal Women Diagnosed with Lichen Sclerosus. Sci. Rep. 2021, 11, 15999. [Google Scholar] [CrossRef]
- Lin, W.-C.; Chen, Y.-R.; Chuang, C.-M.; Chen, J.-Y. A Cationic Amphipathic Tilapia Piscidin 4 Peptide-Based Antimicrobial Formulation Promotes Eradication of Bacterial Vaginosis-Associated Bacterial Biofilms. Front. Microbiol. 2022, 13, 806654. [Google Scholar] [CrossRef] [PubMed]
- Brotman, R.M.; Klebanoff, M.A.; Nansel, T.R.; Yu, K.F.; Andrews, W.W.; Zhang, J.; Schwebke, J.R. Bacterial Vaginosis Assessed by Gram Stain and Diminished Colonization Resistance to Incident Gonococcal, Chlamydial, and Trichomonal Genital Infection. J. Infect. Dis. 2010, 202, 1907–1915. [Google Scholar] [CrossRef] [PubMed]
- Cohen, C.R.; Lingappa, J.R.; Baeten, J.M.; Ngayo, M.O.; Spiegel, C.A.; Hong, T.; Donnell, D.; Celum, C.; Kapiga, S.; Delany, S.; et al. Bacterial Vaginosis Associated with Increased Risk of Female-to-Male HIV-1 Transmission: A Prospective Cohort Analysis among African Couples. PLoS Med. 2012, 9, e1001251. [Google Scholar] [CrossRef] [PubMed]
- De Melo, S.C.C.S.; Costa, A.B.; da Silva, F.T.R.; Silva, N.M.M.G.; Tashima, C.M.; Cardoso, R.F.; de Pádua, R.A.F.; Previdelli, I.; Carvalho, M.D.d.B.; Pelloso, S.M. Prevalence of Streptococcus Agalactiae Colonization in Pregnant Women from the 18th Health Region of Paraná State. Rev. Inst. Med. Trop. Sao Paulo 2018, 60, e2. [Google Scholar] [CrossRef]
| Clinical or Sociodemographic Aspect | Absence of GBS and SAG (327) %Positive (n) | Presence of GBS (47) %Positive (n) | Presence of SAG (17) %Positive (n) | p-Value |
|---|---|---|---|---|
| Mean age | 30.4 | 31.2 | 32.4 | N/A |
| Median age | 30 | 31 | 32 | N/A |
| Age standard deviation | 6.9 | 6.3 | 7.1 | N/A |
| Black/brown ethnicity | 61.8% (201/305) | 72.3% (34/48) | 68.7% (11/16) | 0.3001 |
| White ethnicity | 33.4% (102/305) | 25% (12/48) | 31.2% (5/16) | 0.5321 |
| Diabetes | 48.7% (152/312) | 53.2% (25/48) | 64.7% (11/17) | 0.0602 |
| Arterial hypertension | 20.2% (63/312) | 31.9% (15/48) | 41.2% (7/17) | 0.0056 |
| Hypothyroidism | 5.1% (16/312) | 8.5% (4/48) | 11.8% (2/17) | 0.1990 |
| Sexually transmitted infection | 9.8% (30/306) | 6.4% (3/48) | 18.7% (3/16) | 0.0135 |
| Vaginal discharge | 23.9% (74/310) | 29.8% (14/48) | 29.4% (5/17) | 0.5967 |
| Urinary tract infection | 30.4% (95/312) | 17.0% (8/48) | 56.2% (9/16) | <0.0001 |
| Use of antibiotics | 38.2% (118/309) | 27.6% (13/48) | 50.0% (8/16) | 0.0060 |
| Previous preterm birth | 10.7% (33/309) | 19.1% (9/48) | 5.9% (1/17) | 0.0170 |
| Previous miscarriage | 22.9% (71/309) | 31.9% (15/48) | 23.5% (4/17) | 0.2458 |
| Previous stillbirth | 8.7% (27/309) | 4.2% (2/48) | 5.9% (1/17) | 0.3438 |
Disclaimer/Publisher’s Note: The statements, opinions and data contained in all publications are solely those of the individual author(s) and contributor(s) and not of MDPI and/or the editor(s). MDPI and/or the editor(s) disclaim responsibility for any injury to people or property resulting from any ideas, methods, instructions or products referred to in the content. |
© 2024 by the authors. Licensee MDPI, Basel, Switzerland. This article is an open access article distributed under the terms and conditions of the Creative Commons Attribution (CC BY) license (https://creativecommons.org/licenses/by/4.0/).
Share and Cite
Costa, N.S.; Oliveira, L.M.A.; Rio-Tinto, A.; Pinto, I.B.F.; Oliveira, A.E.A.S.; Santana, J.d.D.; Santos, L.F.; Costa, R.S.N.; Marinho, P.S.; Fracalanzza, S.E.L.; et al. Anovaginal Colonization by Group B Streptococcus and Streptococcus anginosus among Pregnant Women in Brazil and Its Association with Clinical Features. Antibiotics 2024, 13, 85. https://doi.org/10.3390/antibiotics13010085
Costa NS, Oliveira LMA, Rio-Tinto A, Pinto IBF, Oliveira AEAS, Santana JdD, Santos LF, Costa RSN, Marinho PS, Fracalanzza SEL, et al. Anovaginal Colonization by Group B Streptococcus and Streptococcus anginosus among Pregnant Women in Brazil and Its Association with Clinical Features. Antibiotics. 2024; 13(1):85. https://doi.org/10.3390/antibiotics13010085
Chicago/Turabian StyleCosta, Natalia Silva, Laura Maria Andrade Oliveira, Andre Rio-Tinto, Isabella Bittencourt Ferreira Pinto, Ana Elisa Almeida Santos Oliveira, Julia de Deus Santana, Laiane Ferreira Santos, Rayssa Santos Nogueira Costa, Penelope Saldanha Marinho, Sergio Eduardo Longo Fracalanzza, and et al. 2024. "Anovaginal Colonization by Group B Streptococcus and Streptococcus anginosus among Pregnant Women in Brazil and Its Association with Clinical Features" Antibiotics 13, no. 1: 85. https://doi.org/10.3390/antibiotics13010085
APA StyleCosta, N. S., Oliveira, L. M. A., Rio-Tinto, A., Pinto, I. B. F., Oliveira, A. E. A. S., Santana, J. d. D., Santos, L. F., Costa, R. S. N., Marinho, P. S., Fracalanzza, S. E. L., Teixeira, L. M., & Pinto, T. C. A. (2024). Anovaginal Colonization by Group B Streptococcus and Streptococcus anginosus among Pregnant Women in Brazil and Its Association with Clinical Features. Antibiotics, 13(1), 85. https://doi.org/10.3390/antibiotics13010085

